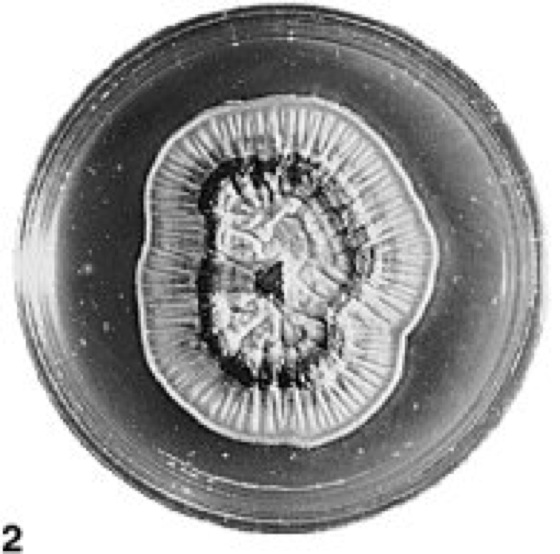

Redaktion Rolf Sauermost (Projektleiter)
Doris Freudig (Redakteurin)
Erweiterte Redaktion Dr. Michael Bonk (Assistenz)
Dr. Andreas Sendtko (Assistenz)
Dr. Helmut Genaust (Etymologische Bearbeitung)
Dr. Claudia Gack (Bildtafelredaktion)
Grafik: Hermann Bausch
Dr. Michael Bonk (EDV)
Wolfgang Hanns
Laura C. Hartmann (EDV)
Professor Dr. Rüdiger Hartmann (EDV)
Klaus Hemmann
Manfred Himmler
Rudolf Kempf (EDV)
Martin Lay (EDV)
Rolf Sauermost (EDV)
Dr. Richard Schmid
Hanns Strub
Melanie Waigand-Brauner (EDV)
CD-ROM-Ausgabe: Doris Freudig (Redaktion und Konzeption)
Richard Zinken (Beratung)
Berater Prof. Dr. Arno Bogenrieder (Botanik)
Prof. Dr. Klaus-Günter Collatz (Zoologie)
Prof. Dr. Hans Kössel (†) (Biochemie, Molekularbiologie)
Prof. Dr. Uwe Maier (Biochemie, Molekularbiologie)
Prof. Dr. Günther Osche (Zoologie)
Prof. Dr. Georg Schön (Mikrobiologie)
Autoren[abc] [def] [ghi] [jkl] [mno] [pqr] [stuv] [wxyz]
Anhäuser, Marcus (M.A.)
Arnheim, Dr. Katharina (K.A.)
Becker-Follmann, Dr. Johannes (J.B.-F.)
Bensel, Dr. Joachim (J.Be.)
Bergfeld (†), Dr. Rainer (R.B.)
Berthold, Prof. Dr. Peter (P.B.)
Bogenrieder, Prof. Dr. Arno (A.B.)
Bohrmann, PD Dr. Johannes (J.B.)
Bonk, Dr. Michael (M.B.)
Born, Prof. Dr. Jan (J.Bo.)
Braun, Andreas (A.Br.)
Bürger, Prof. Dr. Renate (R.Bü.)
Cassada, Dr. Randall (R.C.)
Collatz, Prof. Dr. Klaus-Günter (K.-G.C.)
Culmsee, Dr. Carsten (C.C.)
Drews, Dr. Martina (M.D.)
Drossé, Inke (I.D.)
Duell-Pfaff, Dr. Nixe (N.D.)
Duffner, Dr. Klaus (K.D.)
Eibl-Eibesfeldt, Prof. Dr. Irenäus (I.E.)
Eisenhaber, Dr. Frank (F.E.)
Emschermann, Dr. Peter (P.E.)
Engelbrecht, Beate (B.E.)
Engeser, PD Dr. Theo (T.E.)
Eurich, Dr. Christian (C.E.)
Ewig, Bettina (B.Ew.)
Fässler, Dr. Peter (P.F.)
Fehrenbach, Dr. Heinz (H.F.)
Fix, Dr. Michael (M.F.)
Flemming, Alexandra (A.F.)
Franzen, Dr. Jens Lorenz (J.F.)
Freudig, Doris (D.F.)
Gack, Dr. Claudia (C.G.)
Gallenmüller, Dr. Friederike (F.G.)
Ganter, Sabine (S.G.)
Gärtig, Susanne (S.Gä.)
Gärtner, PD Dr. Wolfgang (W.G.)
Gassen, Prof. Dr. Hans-Günter
Geinitz, Christian (Ch.G.)
Genth, Dr. Harald (H.G.)
Gläser, Dr. Birgitta (B.G.)
Götting, Prof. Dr. Klaus-Jürgen (K.-J.G.)
Grasser, Dr. habil. Klaus (K.G.)
Grieß, Dr. Eike (E.G.)
Grüttner, Dr. Astrid (A.G.)
Häbe, Martina (M.Hä.)
Haken, Prof. Dr. Hermann
Hanser, Dr. Hartwig (H.Ha.)
Harder, Deane Lee (D.Ha.)
Hartmann, Prof. Dr. Rüdiger (R.H.)
Hassenstein, Prof. Dr. Bernhard (B.H.)
Haug-Schnabel, PD Dr. Gabriele (G.H.-S.)
Hemminger, Dr. habil. Hansjörg (H.H.)
Herbstritt, Dr. Lydia (L.H.)
Hobom, Dr. Barbara (B.Ho.)
Hoffrichter, Dr. Odwin (O.H.)
Hohl, Dr. Michael (M.H.)
Hoos, Katrin (K.H.)
Horn, Dagmar (D.H.)
Horn, Prof. Dr. Eberhard (E.H.)
Huber, Christoph (Ch.H.)
Huber, Dr. Gerhard (G.H.)
Huber, Prof. Dr. Robert
Hug, Dr. Agnes M. (A.H.)
Illerhaus, Dr. Jürgen (J.I.)
Illes, Prof. Dr. Peter (P.I.)
Illing, Prof. Dr. Robert-Benjamin (R.B.I.)
Irmer, Juliette (J.Ir.)
Jaekel, Dr. Karsten
Jäger, Dr. Rudolf
Jahn, Dr. Ilse
Jahn, Prof. Dr. Theo (T.J.)
Jendritzky, Prof. Dr. Gerd (G.J.)
Jendrsczok, Dr. Christine (Ch.J.)
Jerecic, Renate (R.J.)
Jordan, Dr. Elke (E.J.)
Just, Dr. Lothar (L.J.)
Just, Margit (M.J.)
Kary, Michael (M.K.)
Kaspar, Dr. Robert
Kattmann, Prof. Dr. Ulrich (U.K.)
Kindt, Silvan (S.Ki.)
Kirchner, Prof. Dr. Wolfgang (W.K.)
Kirkilionis, Dr. Evelin (E.K.)
Kislinger, Claudia (C.K.)
Klein-Hollerbach, Dr. Richard (R.K.)
Klonk, Dr. Sabine (S.Kl.)
Kluge, Prof. Dr. Friedrich (F.K.)
König, Dr. Susanne (S.Kö.)
Körner, Dr. Helge (H.Kör.)
Kössel (†), Prof. Dr. Hans (H.K.)
Kühnle, Ralph (R.Kü.)
Kuss (†), Prof. Dr. Siegfried (S.K.)
Kyrieleis, Armin (A.K.)
Lahrtz, Stephanie (S.L.)
Lamparski, Prof. Dr. Franz (F.L.)
Landgraf, Dr. Uta (U.L.)
Lange, Prof. Dr. Herbert (H.L.)
Lange, Jörg
Langer, Dr. Bernd (B.La.)
Larbolette, Dr. Oliver (O.L.)
Laurien-Kehnen, Dr. Claudia (C.L.)
Lay, Dr. Martin (M.L.)
Lechner-Ssymank, Brigitte (B.Le.)
Leinberger, Annette (A.L.)
Leven, Prof. Franz-Josef (F.J.L.)
Liedvogel, Prof. Dr. Bodo (B.L.)
Littke, Dr. habil. Walter (W.L.)
Loher, Prof. Dr. Werner (W.Lo.)
Lützenkirchen, Dr. Günter (G.L.)
Mack, Dr. Frank (F.M.)
Mahner, Dr. Martin (M.Ma.)
Maier, PD Dr. Rainer (R.M.)
Maier, Prof. Dr. Uwe (U.M.)
Marksitzer, Dr. René (R.Ma.)
Markus, Prof. Dr. Mario (M.M.)
Martin, Dr. Stefan (S.Ma.)
Medicus, Dr. Gerhard (G.M.)
Mehler, Ludwig (L.M.)
Mehraein, Dr. Susan (S.Me.)
Meier, Kirstin (K.M.)
Meineke, Sigrid (S.M.)
Mohr, Prof. Dr. Hans (H.M.)
Mosbrugger, Prof. Dr. Volker (V.M.)
Mühlhäusler, Andrea (A.M.)
Müller, Dr. Ralph (R.Mü.)
Müller, Ulrich (U.Mü.)
Müller, Wolfgang Harry (W.H.M.)
Murmann-Kristen, Dr. Luise (L.Mu.)
Mutke, Jens (J.M.)
Narberhaus, Ingo (I.N.)
Neub, Dr. Martin (M.N.)
Neumann, Dr. Harald (H.Ne.)
Neumann, Prof. Dr. Herbert (H.N.)
Nick, PD Dr. Peter (P.N.)
Nörenberg, Prof. Dr. Wolfgang (W.N.)
Nübler-Jung, Prof. Dr. Katharina (K.N.)
Oehler, Prof. Dr. Jochen (J.Oe.)
Oelze, Prof. Dr. Jürgen (J.O.)
Olenik, Dr. Claudia (C.O.)
Osche, Prof. Dr. Günther (G.O.)
Panesar, Arne Raj
Panholzer, Bärbel (B.P.)
Paul, PD Dr. Andreas (A.P.)
Paulus, Prof. Dr. Hannes (H.P.)
Pfaff, Dr. Winfried (W.P.)
Pickenhain, Prof. Dr. Lothar (L.P.)
Probst, Dr. Oliver (O.P.)
Ramstetter, Dr. Elisabeth (E.R.)
Ravati, Alexander (A.R.)
Rehfeld, Dr. Klaus (K.Re.)
Reiner, Dr. Susann Annette (S.R.)
Riede, Dr. habil. Klaus (K.R.)
Riegraf, Dr. Wolfgang (W.R.)
Riemann, Prof. Dr. Dieter
Roth, Prof. Dr. Gerhard
Rübsamen-Waigmann, Prof. Dr. Helga
Sachße (†), Dr. Hanns (H.S.)
Sander, Prof. Dr. Klaus (K.S.)
Sauer, Prof. Dr. Peter (P.S.)
Sauermost, Elisabeth (E.Sa.)
Sauermost, Rolf (R.S.)
Schaller, Prof. Dr. Friedrich
Schaub, Prof. Dr. Günter A. (G.Sb.)
Schickinger, Dr. Jürgen (J.S.)
Schindler, Dr. Franz (F.S.)
Schindler, Dr. Thomas (T.S.)
Schley, Yvonne (Y.S.)
Schling-Brodersen, Dr. Uschi
Schmeller, Dr. Dirk (D.S.)
Schmitt, Prof. Dr. Michael (M.S.)
Schmuck, Dr. Thomas (T.Schm.)
Scholtyssek, Christine (Ch.S.)
Schön, Prof. Dr. Georg (G.S.)
Schönwiese, Prof. Dr. Christian-Dietrich (C.-D.S.)
Schwarz, PD Dr. Elisabeth (E.S.)
Seibt, Dr. Uta
Sendtko, Dr. Andreas (A.Se.)
Sitte, Prof. Dr. Peter
Spatz, Prof. Dr. Hanns-Christof (H.-C.S.)
Speck, Prof. Dr. Thomas (T.Sp.)
Ssymank, Dr. Axel (A.S.)
Starck, PD Dr. Matthias (M.St.)
Steffny, Herbert (H.St.)
Sternberg, Dr. Klaus (K.St.)
Stöckli, Dr. Esther (E.St.)
Streit, Prof. Dr. Bruno (B.St.)
Strittmatter, PD Dr. Günter (G.St.)
Stürzel, Dr. Frank (F.St.)
Sudhaus, Prof. Dr. Walter (W.S.)
Tewes, Prof. Dr. Uwe
Theopold, Dr. Ulrich (U.T.)
Uhl, Dr. Gabriele (G.U.)
Unsicker, Prof. Dr. Klaus (K.U.)
Vaas, Rüdiger (R.V.)
Vogt, Prof. Dr. Joachim (J.V.)
Vollmer, Prof. Dr. Dr. Gerhard (G.V.)
Wagner, Prof. Dr. Edgar (E.W.)
Wagner, Eva-Maria
Wagner, Thomas (T.W.)
Wandtner, Dr. Reinhard (R.Wa.)
Warnke-Grüttner, Dr. Raimund (R.W.)
Weber, Dr. Manfred (M.W.)
Wegener, Dr. Dorothee (D.W.)
Weth, Dr. Robert (R.We.)
Weyand, Anne (A.W.)
Weygoldt, Prof. Dr. Peter (P.W.)
Wicht, PD Dr. Helmut (H.Wi.)
Wickler, Prof. Dr. Wolfgang
Wild, Dr. Rupert (R.Wi.)
Wilker, Lars (L.W.)
Wilmanns, Prof. Dr. Otti
Wilps, Dr. Hans (H.W.)
Winkler-Oswatitsch, Dr. Ruthild (R.W.-O.)
Wirth, Dr. Ulrich (U.W.)
Wirth, Prof. Dr. Volkmar (V.W.)
Wolf, Dr. Matthias (M.Wo.)
Wuketits, Prof. Dr. Franz M. (F.W.)
Wülker, Prof. Dr. Wolfgang (W.W.)
Zähringer, Dr. Harald (H.Z.)
Zeltz, Dr. Patric (P.Z.)
Ziegler, Prof. Dr. Hubert
Ziegler, Dr. Reinhard (R.Z.)
Zimmermann, Prof. Dr. Manfred
Zissler, Dr. Dieter (D.Z.)
Zöller, Thomas (T.Z.)
Zompro, Dr. Oliver (O.Z.)

Wenn Sie inhaltliche Anmerkungen zu diesem Artikel haben, können Sie die Redaktion per E-Mail informieren. Wir lesen Ihre Zuschrift, bitten jedoch um Verständnis, dass wir nicht jede beantworten können.